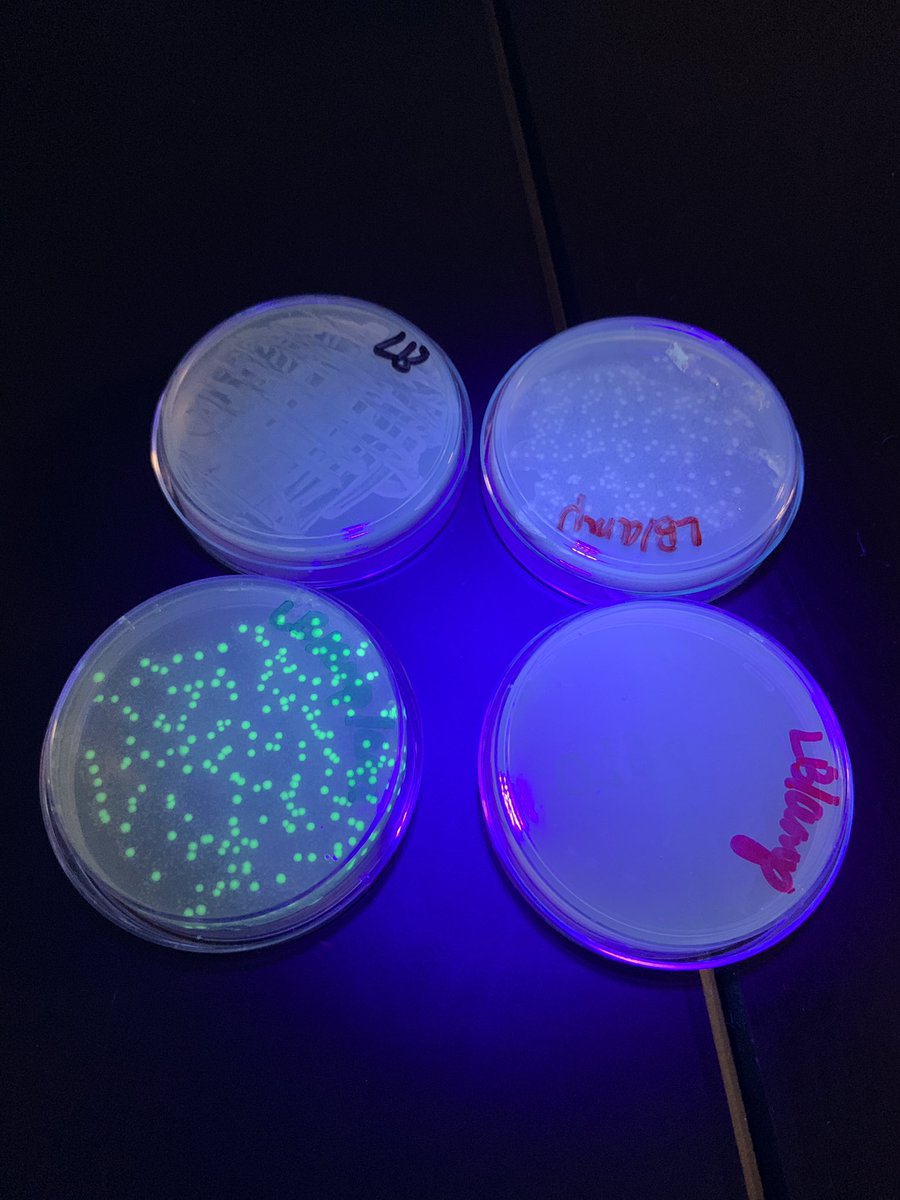
Sherri Wagner tweet media

Way to represent CRHS and Katy ISD! Thank you for going over and beyond to make a difference for students! @kaye1332 @kimteacheschem @SecScienceKISD @katyisd
Bree BarnettDreyfuss@BarnettDreyfuss
Meghan DiBacco presenting how she used Vernier motion tracking with her students at #AAPTWM25
English